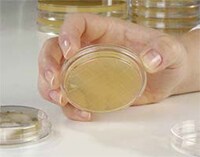
analysis-and-quality-huanjingjiance-2 analysis-and-quality-huanjingjiance-2

Search
Search
工艺质量分析对于生物制药的生产至关重要,并且贯穿整个流程。在前期阶段,生物制药研发过程中需要分析测试,工艺开发与放大过程中,更需要质量控制把关。例如:序列完整性和后修饰决定了细胞株的筛选;糖基化,电荷特性,表达量,聚体等参数可以监控细胞培养工艺;从残留分析等来看纯化工艺是否可行等等。赛默飞提供极其广泛的平台和解决方案组合,可满足您自药物发现到QA/QC的各种分析需求。
完整蛋白表征是蛋白质药物产品(如单抗)研发与质控中很常进行的分析项目。
| • 整体分子量 | • 轻重链分子量 | • 单抗寡糖信息 | • ADC 分子量及DAR 值分析 |
ESI-OrbitrapMS(电喷雾离子化-静电场轨道阱质谱)已经成为很常用的测量方法之一,而另一种常见质谱技术MALDI—TOF(基质辅助激光解析-飞行时间质谱)无法进行此项分析,其原因是由于:在MALDI条件下,蛋白将主要形成单电荷离子,而目前很尖端的TOF型质谱在高质荷比范围分析中(10万m/z以上范围),分辨率也仅有数千。因此当面对质量巨大的蛋白质药物离子时(如单抗分子量近15万),TOF分辨率明显不足,不但无法进行分子量的精确测定,甚至连单抗的糖型也根本无法辨别。
在单抗类药物中,抗体-化学药物偶联物(Antibody-Drug Conjugate, ADC)利用抗体对靶细胞的特异性结合力,输送高细胞毒性化学药物,来实现对癌变细胞的有效杀伤。目前,经FDA已批准上市的ADC药物有三种,分别为Mylotarg™、Adcetris™,Kadcyla™,分别治疗急性髓系白血病,霍奇金淋巴瘤,以及HER2阳性的转移性乳腺癌。全分子量测量技术也可用于ADC药物的DAR(Drug to Antibody Ratio)值分析。
在蛋白质药物产品的质控要求中,需要对蛋白氨基酸序列进行确证,对相关修饰进行鉴定以及定量——即肽图分析。
肽图的液质实验流程主要包括:蛋白的变性、二硫键的还原与烷基化、以及蛋白酶酶解(通常使用胰蛋白酶Trypsin)、液质联用数据采集、数据处理几个步骤。





|
|
二硫键是单抗轻重链之间链半胱氨酸残基中的键,为了确定蛋白质的一级结构,首先必须将二硫键打开,使成为线状多肽链。二硫键对稳定蛋白质药物的空间结构,保持其活性具备重大的作用。主要检测是为了:1)对期望二硫键连接的验证;2)对位置(错配)二硫键的发现。
传统的二硫键分析与二硫键的直接分析法对比发现,传统的方式灵敏度差、分析通量低、不同分析人员造成的分析结果差异较大。目前二硫键分析工作,已经进入了直接分析阶段,也就是直接采集非还原蛋白质药物肽图串联质谱数据,并通过化软件自动化查找二硫键。
在二硫键的质谱分析中,碰撞诱导解离(CID)与高能碰撞解离(HCD)是很普遍的分析方法。ETD 技术作为与CID/HCD 并列的多肽碎裂技术,其碎片特性与后两者有着明显的不同。
二硫键的解析对软件的要求很高,需要有极其强大的数据处理性能。在Biopharma Finder™软件中整合了PepFinder™,它是来源于Amgen内部的的自制的肽图分析软件,因此其功能设计从一开始就听从了一线分析人员的切实需求,而Thermo Fisher的加入,则使软件底层对质谱数据处理的性能大大提高。
|
|
|
|
结合了弱阴离子交换WAX 和亲水相互作用HILIC (AXH-1)/ 反相RP (AXR-1) 两种保留机理,能够高效率地分析复杂寡糖链混合样本。经典 HILIC/RP 机理可以根据电荷数、极性、大小实现寡糖链分离,而 WAX 机理保留和选择带负电荷的寡糖链,对含唾液酸的寡糖链具有很好的分离效果。
可用于检测未标记的聚糖分子。无论被检测物质是何种化学结构,该检测器的分析结果都一致,而且检测动态范围达四个数量级。


以Q-Exactive为代表的静电场轨道阱Orbitrap具有10万以上的超高分辨率和amol级的超高灵敏度,结合高能碎裂(HCD)模式,能获得丰富的碎片信息,并高效分辨和检测寡糖。通过牛胎球蛋白三天线复杂型N-糖链的二级质谱分析(图A)可以看出,即使是寡糖链没有被标记,谱图仍然获得了丰富的高强度碎片信号,特别是B/Y、C/Z等跨环断裂信息,对寡糖链精细结构的解析具有重要作用。实验在牛胎球蛋白中成功解析了29种不同结构的N-糖链(图B),其中绝大部分为含唾液酸的寡糖链,证明UHPLC-Orbitrap对复杂寡糖链的强大分析能力。
牛胎球蛋白N- 糖链二级谱图质谱解析示例(A) 与解析结果汇总(B)
GlycanAssure HyPerformanceAPTS Kit工作流程
N- 糖基化位点鉴定通常使用PNGase F酶释放糖链,使肽段上产生去糖基化位点,并在肽段上产生去糖基化痕迹:天冬酰胺(N)发生脱氨基化,造成0.9840 Da 的质量增加。通过质谱寻找发生+0.9840 Da 的天冬酰胺,以及N- 糖基化保守序列NXS/T (X 代表脯氨酸以外的任何氨基酸) 过滤,获得可信的鉴定结果(下 图)。为了避免天然脱氨基化造成的假阳性,可以在18O 水中进行酶切,使去糖基化位点含有一个18O, 形成+2.9890Da,可与天然脱氨基区分。
Orbitrap 由于具有超高分辨率和超高灵敏度,无论对于单抗等纯蛋白样品、还是全细胞蛋白等复杂样品, 都是是糖基化位点表征的很好工具。
PNGase F 酶切鉴定糖基化位点原理
糖肽分析前处理简单,能同时鉴定糖基化位点和解析寡糖链结构,并获得位点特异性糖链信息,即微观不均一性。但是糖肽解析比糖链与糖肽分开解析的传统方法更为复杂。
|
|
|
|
Orbitrap 质量分析器与HCD 高能碎裂能有效应对复杂未知糖肽解析的挑战。在谱图分析阶段,Byonic™ 可以实现复杂糖肽谱图的全自动数据处理,解析肽段骨架序列和寡糖链结构。
右图展示了糖肽EEQYNSTYR 的谱图解析结果,谱图中存在着丰富的糖肽碎片离子,并获得超高质量精度的可靠匹配,确定糖链结构为G0F。
蛋白质电荷的均匀性对蛋白药物结构、稳定性、亲和力和疗效有着非常重要的影响。通常使用离子交换 色谱法(IEX),通过盐梯度或pH 梯度进行分离。
|
|
质谱监测是蛋白药物代谢定量分析的最后一环,也是关键一环。目前通常采用两类质谱进行此类分析: 三重四极杆质谱(QQQ)与 四极杆 - 静电场轨道阱质谱(Q-Orbitrap)。两种质谱分别使用选择反应监 测质谱法(Select Reaction Monitor,SRM)与平行反应监测(Parallel Reaction Monitoring,PRM)质 谱法。
UHPLC 能够提供更快的运行、更高的分离度以及更低的运行成本,满足更多实验室各种不同应用的需求。赛默飞所有型号的HPLC 系统都具备常规分析及快速分析的功能, 为您的分析需求提供更强的多功能性。
该系列是我们所有知识和热情的结晶,提供前所未有的革命性的色谱体验。您可得到更好的结果、更多的信息、更强 的人机交互。
该系统(RSLC)集成了超快速分离所需的独特硬件,使用小颗粒填料色谱柱实现了卓越的分离度。
Q Exactive UHMR高分辨质谱仪很大质量范围可达80,000,广泛应用于结构生物学和生物制药研究。非变性质谱(MS)是研究大型蛋白复合体、蛋白质相互作用和蛋白配体间相互作用的强大技术。该方法在 MS 分析中保持生物分子的自然折叠状态及关联的非共价相互作用。Q Exactive UHMR 组合型四极杆-Oribitrap 质谱仪是首款将前所未有的超高质量数范围分辨率、超高灵敏度及 MS2 和 pseudo-MS3 性能进行独一无二的结合,以超越现今非变性质谱实验所能。
该系统提供了很合适的解决方案,适用于严苛的分析型和半制备型LC 应用。
该系统是真正适用于蛋白质、多肽和生物治疗药物分析的生物型UHPLC。非常适合于生物制药的开发、鉴定以及质量控制(QC)。
Orbitrap 技术是公认的赛默飞的独特技术,被用于高分辨的质谱分析平台。Q Exactive 质谱系列将HRAM的定性和定量功能集成到同一台质谱中,仅用一台质谱仪就能实现化合物的鉴定,定量和确证。

Thermo Scientific™ Exactive™ Plus 质谱仪操作 简便、性价比高,结合工作流程驱动软件,是针对新用户和执行大量常规分析用户的理想仪器。 它可进行高分辨率、精确质量(HRAM)全扫描 MS,提供快速、精确、可重复的结果,让分析结果高度可信。连续采集 HRAM 全扫描数据可进行定性和定量的回顾数据分析。

组合型四极杆Orbitrap 质谱仪提供的灵敏度、选择性、灵活性及易用性为目标和非目标化合物的筛选、定量、鉴定和确证设立了标准。
Thermo Scientific™ Q Exactive/ Focus 组合型四极杆OrbitrapMS 将上述功能应用于环境、食品安全、临床研究、法医毒理学分析及受样品容量增加和预算严格受限挑战的制药实验室。Q Exactive/ Focus 系统可靠提供无与伦比的结果,以简化方法开发,节省时间,降低成本。

Thermo Scientific™ Q Exactive™ Plus 台式 LCMS/ MS 质谱仪将高性能四极杆的母离子高选择性与高分辨率、精确质量(HRAM)的Orbitrap检测相结合,提供卓越的性能和广泛的多功能性。 从蛋白质表征到靶向或基于DIA 的定量及DMPK 定性/ 定量筛选研究,该系统均可让您快速在复杂样品中筛选、鉴定和定量化合物。

Thermo Scientific™ Q Exactive™ HF质谱仪是新 一代HRAM台式系统,配超高场Orbitrap检测器, 为定性和定量组学工作流程提供更高的速度、生产率和可信度。

Orbitrap Fusion超高分辨质谱系统是世界上第一 款“ 三合一” 质谱,该系统革命性地将四极杆Q(Quadrupole)、静电场轨道阱OT(Orbitrap)、 双压线性离子阱Velos Pro(Linear Ion Trap)三种质量分析器和两个检测器(Orbitrap、双压线性离子阱)集为一体,并利用创新的动态扫描管理技术实现三种质量分析器的同时工作并相互协作,实现真正意义上的平行检测或序列检测, 多级分析的任何一级都可以随使用者的喜好来进行CID、HCD或ETD的碎裂模式选择,达到很高的分析效率和很好的选择。

新型Thermo Scientific™ OrbitrapFusion™ Lumos™ Tribrid™ 质谱仪通过先进的性能扩大先进蛋白组学、生物制药和代谢组学的应用,包括应用同位素标记定量、低水平PTM 分析、数据非依赖采集(DIA)和“ 自上而下” 的蛋白组学研究。该仪器灵敏度高,提高了分析物检测、 鉴定和定量水平,使科学家能够更快速和更全面地进行样品分析,提供前所未有的准确度。
基于液相- 质谱(LC-MS)联用在生物制药表征中是很常见的一种分析方法,可以测定完整蛋白分子量,肽图及修饰分析,糖型分析,二硫键解析,N-/C- 端确认,药物代谢分析等。我们在分析的过程中,不仅 需要出色的液相分离,还需要高分辨率的质谱进行鉴定。
专为Fisher Chemical 溶剂设计的FisherLOCK 瓶盖可用于 500mL、2.5L、4L 溶剂包装瓶,仍然沿用38/439 口规格, 与旧款瓶盖一样可以适配其他相同口径的容器。
质量
| 可靠
|
安全
| 方便
|
变性分离和非变性分离聚丙烯酰胺凝胶电泳,可鉴别复杂样本中的蛋白质或检测单个样本中的多种蛋白质,在生物制药检测过程中常常被用于分子量大小的鉴定。
|
|
| ![]() |


| • 一体机、大视野 | • 智能化、易操作 | • 多重成像通道多 | • 内置软件数据全 |
我们近 2000 种 ELISA 产品全面而便捷的产品组合,范围从即用型包被和未包被 ELISA 试剂盒到定制您的免疫分析而提供的高质量试剂和缓冲剂,以及 ELISA 相 关的仪器和配件。我们的 ELISA 试剂盒已经被超过 5000 篇出版物引用。
我们的 ELISA 试剂盒已被超过 3,000 篇文献引用,符合行业标准规范,包括标准品校准、精确度、灵敏度、特异性、回收率、批次间 一致性、线性度和平行度。
全面且经过验证
这些组件包括抗体、标准、检测试剂和96 孔板,覆膜与捕获抗体。
经济实惠且使用方便
这些试剂盒含有匹配的抗体对、标准和检 测试剂,但要求用户自己涂上捕获抗体。
针对您的需求定制
通过选择你自己的抗体、试剂和其它检测 元件来开发、测试和验证您的直接或间接 酶联免疫吸附试验。
用于ELISA 分析的酶标仪
我们提供了不同的酶标仪,包括Thermo Scientific™ Multiskan™ FC 和Multiskan™ GO 全波长酶标仪,提供的Multiskan™ GO 全波长酶标仪,胜任各种光度测量研究应用,如蛋白质、DNA 和RNA,同时我们直观的用户界面使您可以直接从仪器上运行快速检测。
• 免疫检测(ELISA)、蛋白质分析、内毒素、细胞毒性和增殖检测、酶活测定、生长曲线
DNA 和 RNA 定量和纯度检测、蛋白质检测、酶检测、动力学检测、免疫测定、细胞增殖和细胞毒性检测、 凋亡检测、报告基因检测、GPCR 检测
我们提供与杂质检测相关的试剂盒,以及高通量Kingfisher Flex 磁珠纯化系统并结合荧光定量PCR 平台 来对杂质检测分析的一整套解决方案。
Kingfisher Flex 磁珠纯化系统,可以实现高通量工作,结合相关试剂盒和荧光定量PCR 平台可实现高达 到fg 级高灵敏检测。



突破性的蛋白PCR 技术带来灵敏准确的宿主细胞残留定量检测
现在您可以使用比ELISA 方法拥有更宽检测范围和更高灵敏度的新方法来检测残宿主细胞残留蛋白。 ProteinSEQ™ 宿主残留蛋白检测试剂盒最低可以检测0.2ng /mL 的HCP,它可以帮助我们更精准的检测 在蛋白纯化工艺中各个步骤的HCP 含量。
第一个基于实时定量PCR 原理对宿主细胞残留DNA 快速定量检测的系统
一个优秀的系统通常并不仅仅在一个方面表现出自身的出众,而是在各个方面都出彩,宿主细胞DNA 残留定量系统就这样的一个优秀的高效系统。该系统工作流程简单可以帮助你减少操作,检测结果准确可以帮助你避免样品复测,可自动化操作可以帮助你进行高通量检测。总之,宿主细胞DNA 残留定量系统可以节约你宝贵的时间、精力和资源。
样品
|
每反应加标含量
|
回收率
|
CV
|
典型的纯化中间样品
|
1 pg
|
86%
|
5%
|
典型的抗体药物原液
|
1 pg
|
76%
|
8%
|
resDNASEQ 宿主细胞残留定量试剂盒在复杂基质中的回收率
突破性的蛋白PCR 技术带来灵敏准确的残留蛋白A 定量检测
现在您可以使用比ELISA 方法拥有更宽检测范围和更高灵敏度的新方法来检测残留的蛋白A.ProteinSEQ™ 蛋白A 定量试剂盒最低可以检测2.5 pg /mL 的蛋白A 残留, 它可以帮助我们更精准的检测在蛋白纯化工艺 中各个步骤的蛋白A 残留量。
在生物制药工艺流程中,需要对整个过程中的中间产物及成品药物进行一系列的质控分析,对生物制品的安全性检测主要包括细菌内毒素检测、支原体检测、病毒检测,这些物质的存在不仅会影响药物功效, 而且会对人体健康有害,必须严格控制,以达到FDA/CFDA的监管要求。
Multiskan ET 动态内毒素检测仪传承40年的酶标仪制造经验,在传统酶标仪的基础上,专为内毒素检测优化设计光路,可满足不同鲎试剂检测需求。
第一个基于实时定量PCR 技术对支原体进行检测的系统
支原体是目前已知的最小非寄生生物,是哺乳动物细胞培养中常见的一种污染源。监管的的指导原则是所有来源于哺乳动物细胞的制品都必须检测支原体。目前被监管部门接受的基于培养基的方法的检测周期为28天。2007 年7 月,欧洲药典提出用核酸扩增技术进行支原体检测的指导纲要,用以替代28 天培养法。
第一个基于实时定量PCR 技术的病毒污染物检测综合平台
在细胞培养生产工艺中,病毒污染物是一种常见的潜在威胁。使用基于实时定量PCR 的快速检测技术可 以实现对整个细胞培养生产过程进行实时监控,有助于早期发现污染事件。ViralSEQ™ 病毒检测系统提 供一个检测病毒污染物的灵敏可靠的方法,并对目标病毒污染物如鼠细小病毒和水疱疹病毒表现出很高 的检测特异性。
Human 10 ng
|
Undetected
|
Mouse 500 ng
|
Undetected
|
Rat 370 ng
|
Undetected
|
CHC 500 ng
|
Undetected
|
S. pneumoniae 10 ng
|
Undetected
|
S. cerevisiae 10 ng
|
Undetected
|
S. enterica 10 ng
|
Undetected
|
S. aureus 10 ng
|
Undetected
|
E. coli 10 ng
|
Undetected
|
以上无关DNA 被证明不会被ViralSEQ 鼠细小病毒检测试剂盒检出
双光源专利技术,检出率极高
X 射线异物检测系统 – 西林瓶或安瓿瓶破损时,残留的玻璃碎片将是非 常大的安全隐患。赛默飞专利技术- 侧面照射双光源X 射线检测技术, 可将隐藏在瓶底或贴在瓶壁的碎玻璃或大而薄的玻璃片检测出来。
基于3500 型系列基因分析仪的微生物鉴定全球推荐方法
微生物鉴定全球推荐方法
有害的细菌和真菌不仅可能会污染原料和生产设备,更糟糕的是会污染最终产品,这将为生产带来不可估量的损失。MicroSEQ™ 快速微生物鉴定系统基于基因测序原理准确鉴定细菌和真菌,帮助进行环境监控、污染调查、溯源分析和原材料检测,全面解决微生物污染问题。
3500 基因分析仪通过 DNA 测序技术来帮助检测杂质和鉴定污染,从而迅速成为全球药物分析的遵循标准。 3500 系列数据采集软件在用户友好导航上有了新的突破,它有直接的仪表盘设计、显而易见的常规操作按 钮、易读取的图表显示。
Thermo Scientific™ RapID™ 鉴定系统和ERIC™ 软件可以帮助您对更多微生物进行鉴定,体验更快的鉴定速度、更短的实验时间、更鲜明的彩色反应效果以及更精确的报告。它利用酶学技术,只需四个小时即可得到结果。
一步接种缩短准备时间,提高产率 通用附加试剂少减少材料用量,节省时间和费用 | 四小时孵育*更快获得结果,更快应对 清晰的颜色反应降低主观性,减少重复检测 |


RapID ONE 肠杆菌鉴定板条
| RapID ANA II 厌氧菌鉴定板条
| RapID CB Plus 棒状杆菌鉴定板条
|
RapID STR 链球菌鉴定板条
| RapID NF Plus 非发酵菌鉴定板条
| RapID NH 奈瑟氏菌和嗜血杆菌鉴定板条
|
RapID Yeast Plus 酶母菌鉴定板条
| RapID NF Plus 非发酵菌鉴定板条
| RapID Staph Plus 葡萄球菌鉴定板条
|
|
|


实验配套试剂
| ||
产品号
|
产品名
|
包装
|
GNID
|
Sensititre 革兰阴性菌鉴定板(3 人份/ 块)
|
10 块/ 盒
|
GNID
|
Sensititre 革兰阳性菌鉴定板(3 人份/ 块)
|
10 块/ 盒
|
T3339
|
Sensititre® 去离子水
|
100 支/ 盒
|
其它相关产品
| ||
E1041
|
0.5McFarland 标准管
|
包装
|
E3010
|
Autoinoculator Dosing Heads(AIM 配套加样头)
|
100 个/ 盒
|
采用Nicolet 高灵敏度ATR 附件,可快速无损获得高质量的蛋白质样品谱图,结合Nicolet OMNIC 软件的强大功能,能够实现对蛋白质二级结构的快速分析,获得各结构对应的峰面积值,可获得各条件下蛋白质二级结构的相关信息机变化情况,可以为蛋白质类样品的快速质控提供有力手段,结合其他参考分析数据,可实现对各二级结构的快速定量。
Thermo Scientific Nicolet iS20傅里叶变换红外光谱仪
红外光谱仪采用专利磁浮式干涉仪确保提供最稳定可靠的结果和最卓越的光谱质量,刚石切削整体铸模的光学元件,配合 “对针定位”设计,确保了业界最稳定的数据重复性。利用专业分析软件,可快速获得蛋白质二级结构分析。
Evolution 260 Bio紫外可见分光光度计使用内置的应用模块简化日常核酸、蛋白质分析试验。软件Bio应用模块操作简单,为您提供快速指导。双光束光学设计可同时测量参比和样品,具有可变带宽以及配备满足21 CFR Part 11要求的Thermo Scientific INSIGHT软件INSIGHT安全软件,并可以确切获得瞬间数据可为快速混合动力学测量提供最高的精确度。
独一无二的Acclaro样本智能检测技术

耐用的小型电池驱动旋转粘度计适用于在实验室和生产区进行快速可靠检测和相对粘度测量。
便携式粘度计HAAKE Viscotester 1 Plus 和2 Plus | |
主要特点 | 主要应用 |
|
|
经济实惠且使用方便
这些试剂盒含有匹配的抗体对、标准和检 测试剂,但要求用户自己涂上捕获抗体。
针对您的需求定制
通过选择你自己的抗体、试剂和其它检测 元件来开发、测试和验证您的直接或间接 酶联免疫吸附试验。
用于ELISA 分析的酶标仪
我们提供了不同的酶标仪,包括Thermo Scientific™ Multiskan™ FC 和Multiskan™ GO 全波长酶标仪,提供的Multiskan™ GO 全波长酶标仪,胜任各种光度测量研究应用,如蛋白质、DNA 和RNA,同时我们直观的用户界面使您可以直接从仪器上运行快速检测。
• 免疫检测(ELISA)、蛋白质分析、内毒素、细胞毒性和增殖检测、酶活测定、生长曲线
DNA 和 RNA 定量和纯度检测、蛋白质检测、酶检测、动力学检测、免疫测定、细胞增殖和细胞毒性检测、 凋亡检测、报告基因检测、GPCR 检测
我们提供与杂质检测相关的试剂盒,以及高通量Kingfisher Flex 磁珠纯化系统并结合荧光定量PCR 平台 来对杂质检测分析的一整套解决方案。
Kingfisher Flex 磁珠纯化系统,可以实现高通量工作,结合相关试剂盒和荧光定量PCR 平台可实现高达 到fg 级高灵敏检测。



突破性的蛋白PCR 技术带来灵敏准确的宿主细胞残留定量检测
现在您可以使用比ELISA 方法拥有更宽检测范围和更高灵敏度的新方法来检测残宿主细胞残留蛋白。 ProteinSEQ™ 宿主残留蛋白检测试剂盒最低可以检测0.2ng /mL 的HCP,它可以帮助我们更精准的检测 在蛋白纯化工艺中各个步骤的HCP 含量。
第一个基于实时定量PCR 原理对宿主细胞残留DNA 快速定量检测的系统
一个优秀的系统通常并不仅仅在一个方面表现出自身的出众,而是在各个方面都出彩,宿主细胞DNA 残留定量系统就这样的一个优秀的高效系统。该系统工作流程简单可以帮助你减少操作,检测结果准确可以帮助你避免样品复测,可自动化操作可以帮助你进行高通量检测。总之,宿主细胞DNA 残留定量系统可以节约你宝贵的时间、精力和资源。
样品
|
每反应加标含量
|
回收率
|
CV
|
典型的纯化中间样品
|
1 pg
|
86%
|
5%
|
典型的抗体药物原液
|
1 pg
|
76%
|
8%
|
resDNASEQ 宿主细胞残留定量试剂盒在复杂基质中的回收率
突破性的蛋白PCR 技术带来灵敏准确的残留蛋白A 定量检测
现在您可以使用比ELISA 方法拥有更宽检测范围和更高灵敏度的新方法来检测残留的蛋白A.ProteinSEQ™ 蛋白A 定量试剂盒最低可以检测2.5 pg /mL 的蛋白A 残留, 它可以帮助我们更精准的检测在蛋白纯化工艺 中各个步骤的蛋白A 残留量。
在生物制药工艺流程中,需要对整个过程中的中间产物及成品药物进行一系列的质控分析,对生物制品的安全性检测主要包括细菌内毒素检测、支原体检测、病毒检测,这些物质的存在不仅会影响药物功效, 而且会对人体健康有害,必须严格控制,以达到FDA/CFDA的监管要求。
Multiskan ET 动态内毒素检测仪传承40年的酶标仪制造经验,在传统酶标仪的基础上,专为内毒素检测优化设计光路,可满足不同鲎试剂检测需求。
第一个基于实时定量PCR 技术对支原体进行检测的系统
支原体是目前已知的最小非寄生生物,是哺乳动物细胞培养中常见的一种污染源。监管的的指导原则是所有来源于哺乳动物细胞的制品都必须检测支原体。目前被监管部门接受的基于培养基的方法的检测周期为28天。2007 年7 月,欧洲药典提出用核酸扩增技术进行支原体检测的指导纲要,用以替代28 天培养法。
第一个基于实时定量PCR 技术的病毒污染物检测综合平台
在细胞培养生产工艺中,病毒污染物是一种常见的潜在威胁。使用基于实时定量PCR 的快速检测技术可 以实现对整个细胞培养生产过程进行实时监控,有助于早期发现污染事件。ViralSEQ™ 病毒检测系统提 供一个检测病毒污染物的灵敏可靠的方法,并对目标病毒污染物如鼠细小病毒和水疱疹病毒表现出很高 的检测特异性。
Human 10 ng
|
Undetected
|
Mouse 500 ng
|
Undetected
|
Rat 370 ng
|
Undetected
|
CHC 500 ng
|
Undetected
|
S. pneumoniae 10 ng
|
Undetected
|
S. cerevisiae 10 ng
|
Undetected
|
S. enterica 10 ng
|
Undetected
|
S. aureus 10 ng
|
Undetected
|
E. coli 10 ng
|
Undetected
|
以上无关DNA 被证明不会被ViralSEQ 鼠细小病毒检测试剂盒检出
双光源专利技术,检出率极高
X 射线异物检测系统 – 西林瓶或安瓿瓶破损时,残留的玻璃碎片将是非 常大的安全隐患。赛默飞专利技术- 侧面照射双光源X 射线检测技术, 可将隐藏在瓶底或贴在瓶壁的碎玻璃或大而薄的玻璃片检测出来。
基于3500 型系列基因分析仪的微生物鉴定全球推荐方法
微生物鉴定全球推荐方法
有害的细菌和真菌不仅可能会污染原料和生产设备,更糟糕的是会污染最终产品,这将为生产带来不可估量的损失。MicroSEQ™ 快速微生物鉴定系统基于基因测序原理准确鉴定细菌和真菌,帮助进行环境监控、污染调查、溯源分析和原材料检测,全面解决微生物污染问题。
3500 基因分析仪通过 DNA 测序技术来帮助检测杂质和鉴定污染,从而迅速成为全球药物分析的遵循标准。 3500 系列数据采集软件在用户友好导航上有了新的突破,它有直接的仪表盘设计、显而易见的常规操作按 钮、易读取的图表显示。
Thermo Scientific™ RapID™ 鉴定系统和ERIC™ 软件可以帮助您对更多微生物进行鉴定,体验更快的鉴定速度、更短的实验时间、更鲜明的彩色反应效果以及更精确的报告。它利用酶学技术,只需四个小时即可得到结果。
一步接种缩短准备时间,提高产率 通用附加试剂少减少材料用量,节省时间和费用 | 四小时孵育*更快获得结果,更快应对 清晰的颜色反应降低主观性,减少重复检测 |


RapID ONE 肠杆菌鉴定板条
| RapID ANA II 厌氧菌鉴定板条
| RapID CB Plus 棒状杆菌鉴定板条
|
RapID STR 链球菌鉴定板条
| RapID NF Plus 非发酵菌鉴定板条
| RapID NH 奈瑟氏菌和嗜血杆菌鉴定板条
|
RapID Yeast Plus 酶母菌鉴定板条
| RapID NF Plus 非发酵菌鉴定板条
| RapID Staph Plus 葡萄球菌鉴定板条
|
|
|


实验配套试剂
| ||
产品号
|
产品名
|
包装
|
GNID
|
Sensititre 革兰阴性菌鉴定板(3 人份/ 块)
|
10 块/ 盒
|
GNID
|
Sensititre 革兰阳性菌鉴定板(3 人份/ 块)
|
10 块/ 盒
|
T3339
|
Sensititre® 去离子水
|
100 支/ 盒
|
其它相关产品
| ||
E1041
|
0.5McFarland 标准管
|
包装
|
E3010
|
Autoinoculator Dosing Heads(AIM 配套加样头)
|
100 个/ 盒
|
采用Nicolet 高灵敏度ATR 附件,可快速无损获得高质量的蛋白质样品谱图,结合Nicolet OMNIC 软件的强大功能,能够实现对蛋白质二级结构的快速分析,获得各结构对应的峰面积值,可获得各条件下蛋白质二级结构的相关信息机变化情况,可以为蛋白质类样品的快速质控提供有力手段,结合其他参考分析数据,可实现对各二级结构的快速定量。
Thermo Scientific Nicolet iS20傅里叶变换红外光谱仪
红外光谱仪采用专利磁浮式干涉仪确保提供最稳定可靠的结果和最卓越的光谱质量,刚石切削整体铸模的光学元件,配合 “对针定位”设计,确保了业界最稳定的数据重复性。利用专业分析软件,可快速获得蛋白质二级结构分析。
Evolution 260 Bio紫外可见分光光度计使用内置的应用模块简化日常核酸、蛋白质分析试验。软件Bio应用模块操作简单,为您提供快速指导。双光束光学设计可同时测量参比和样品,具有可变带宽以及配备满足21 CFR Part 11要求的Thermo Scientific INSIGHT软件INSIGHT安全软件,并可以确切获得瞬间数据可为快速混合动力学测量提供最高的精确度。
独一无二的Acclaro样本智能检测技术

耐用的小型电池驱动旋转粘度计适用于在实验室和生产区进行快速可靠检测和相对粘度测量。
便携式粘度计HAAKE Viscotester 1 Plus 和2 Plus | |
主要特点 | 主要应用 |
|
|
赛默飞 iCE3000 系列原子吸收光谱仪(AAS)可以作为铜、镉、铅、砷、汞等药品中有害元素分析控制的有利工具。简单的样品制备流程及快速上手的方法为准确可靠地进行微量和痕量分析提供了高效率的解决方案。



赛默飞TRACE 1300 系列气相色谱仪(GC)首创模块化设计,集超快速、易操作、便携式于一身。ISQ 系列气相色谱- 质谱联用(GC-MS )具有抗污染能力强、灵敏度高、分析快速、操作方便的优势,其“ 永 不停机” 的特性使得高负荷高效率的GC-MS 成为现实。
•全新的TRACE GC 1300 系列气相色谱,业内唯一能实现用户可直接更换的 模块化进样口和检测器的气相色谱仪,减少仪器的维护时间,让用户可以根据 具体的应用及日常分析工作快速提高仪器性,极大改善分析效率
• ISQ™ 系列气相色谱- 质谱联用仪是久经时间考验的单四极杆质谱,代表了质 谱仪在创新方面近50 年的积累,兼备高品质设计、操作简单、高可靠性、高灵 敏度的特点,作为领先的气相色谱- 质谱联用仪技术平台将为您提供永不过时 的投资

赛默飞 iCAP7000 Plus 系列ICP-OES 采用双向观测模式,满足多元素高灵敏度的分析需求
• 记录全波段谱线信息、避免漏测
• 实验参数优化自动化、自动校正波长、可拆卸炬管等设计使仪器操作非常简便
• 在有限时间内可以分析更多的样品

赛默飞 iCAP RQ 电感耦合等离子体质谱仪(ICP-MS)具有多元素同时检测,检测速度快,灵敏度高,动态范围宽的特点,而这些优势则是目前应用更为广泛的石墨炉原子吸收所不具备的
• 低维护、无缆线设计
• 所有连接均位于仪器前方和侧面,可直接靠墙放置

赛默飞ICS 系列离子色谱(IC)在创新、应用及研发等都处于绝对的领先地位, 可以满足您对IC 的任何需求
• 入门级IC 用于常规分析
• 免试剂IC 系统无需人工配制淋洗液,仅用等度泵实现梯度淋洗
• 双系统IC 适合连续分析或复杂方法的开发
• 多种检测器供选择: 抑制电导、安培、紫外可见光、荧光和质谱

赛默飞 Nicolet iS 系列FT-IR 包括iS5, iS10, iS50和 iN10 显微红外光谱仪等4种型号,是药包材检验分析的有力工具
• iS 5 精巧便携,常规分析的首选
• iS10 每秒40 张谱图的快速扫描出类拔萃
• iS50 具备卓越的可扩展性与兼容性,是理想的研究级红外平台
• iN10 是全世界第一台全自动,高智能的显微红外一体机
赛默飞UltiMate™ 3000 系列液相色谱系统(HPLC)和 Vanquish™ 系列UHPLC 系统是分析活性药物成分,药物代谢产物,药物辅料、药包材等的有利工具,无论您有何种需求,我们都可以提供满足您需求的液相色谱系统。
UltiMate 3000 系列HPLC
• 提供独特的双三元液相色谱系统满足您串联、并联和在线样品前处理的多种应用需求;提供二极管阵列、多波长、荧光、CAD 电喷雾、库伦电化学、质谱等多种检测器,满足您对各种复杂成分的检测需求
Vanquish 系列UHPLC
• 高压二元体系泵提供更强的分离能力,耐压1500 bar,流速可达5 mL/min;四元体系泵提供更多的溶剂选择性,耐压亦达1000 bar,流速高达10 mL/min;最多可加载23 块多孔板,容纳8832 份样品;LightPipe™ 技术,扩散更小,更灵敏地检测目标成分
符合 ISO、FDA、USP/JP/EP 等配方要求,品种广泛。
|
|
|
OXOID 成品培养基在英国、澳大利亚、加拿大、中国、新加坡、德国的六大OXOID 培养基工厂生产,为制药行业提供安全,可靠的微生物检测产品。
• 采用OXOID 干粉和进口医用玻璃瓶、胶塞及铝盖生产,提供优秀性能和产品密封性,更安全的液体培养基生产工艺和灭菌工艺,大大降低污染风险
• 每批产品在出厂前均按照cGMP 要求进行无菌及性能检测,所有批次均留样追溯产品的稳定性
• 迄今唯一在国内设立工厂的进口培养基品牌,确保稳定供货;可提供订制化服务
Thermo Scientific™ 质控菌株即用型质控微生物可靠性和一致性。
• 可靠的质量 —— 超过25 年生产质控微生物的经验
• 受控的生产过程
- ISO 认证 - 符合cGMP 要求
- FDA 认证 - ATCC 特许衍生计划成员
• 源自ATCC 培养物的稳定微生物(或其他所述的参考菌株)
• 源培养物有限传代使突变风险较小
快速、安全、简便
| 质量保障
|
Thermo Scientific™ 空气采样器是一种高性能的空气浮游菌采样器,可用于制药、临床、食品生产环境中 微生物污染水平的监测。
| • 使用优质的Oxoid 干粉培养基制成:可提供胰蛋白胨大豆琼脂培养基 (TSA)、沙保氏葡萄糖琼脂培养基(SDA)或其他培养基 | • 一般采用φ90×15mm 规格的培养皿 • 有三层无菌包装产品,无需100% 预培养 |
|
|
我们的分析滤器提供精确、易于使用的系统,用于回收 QC 测试和研究用的微生物和颗粒物。